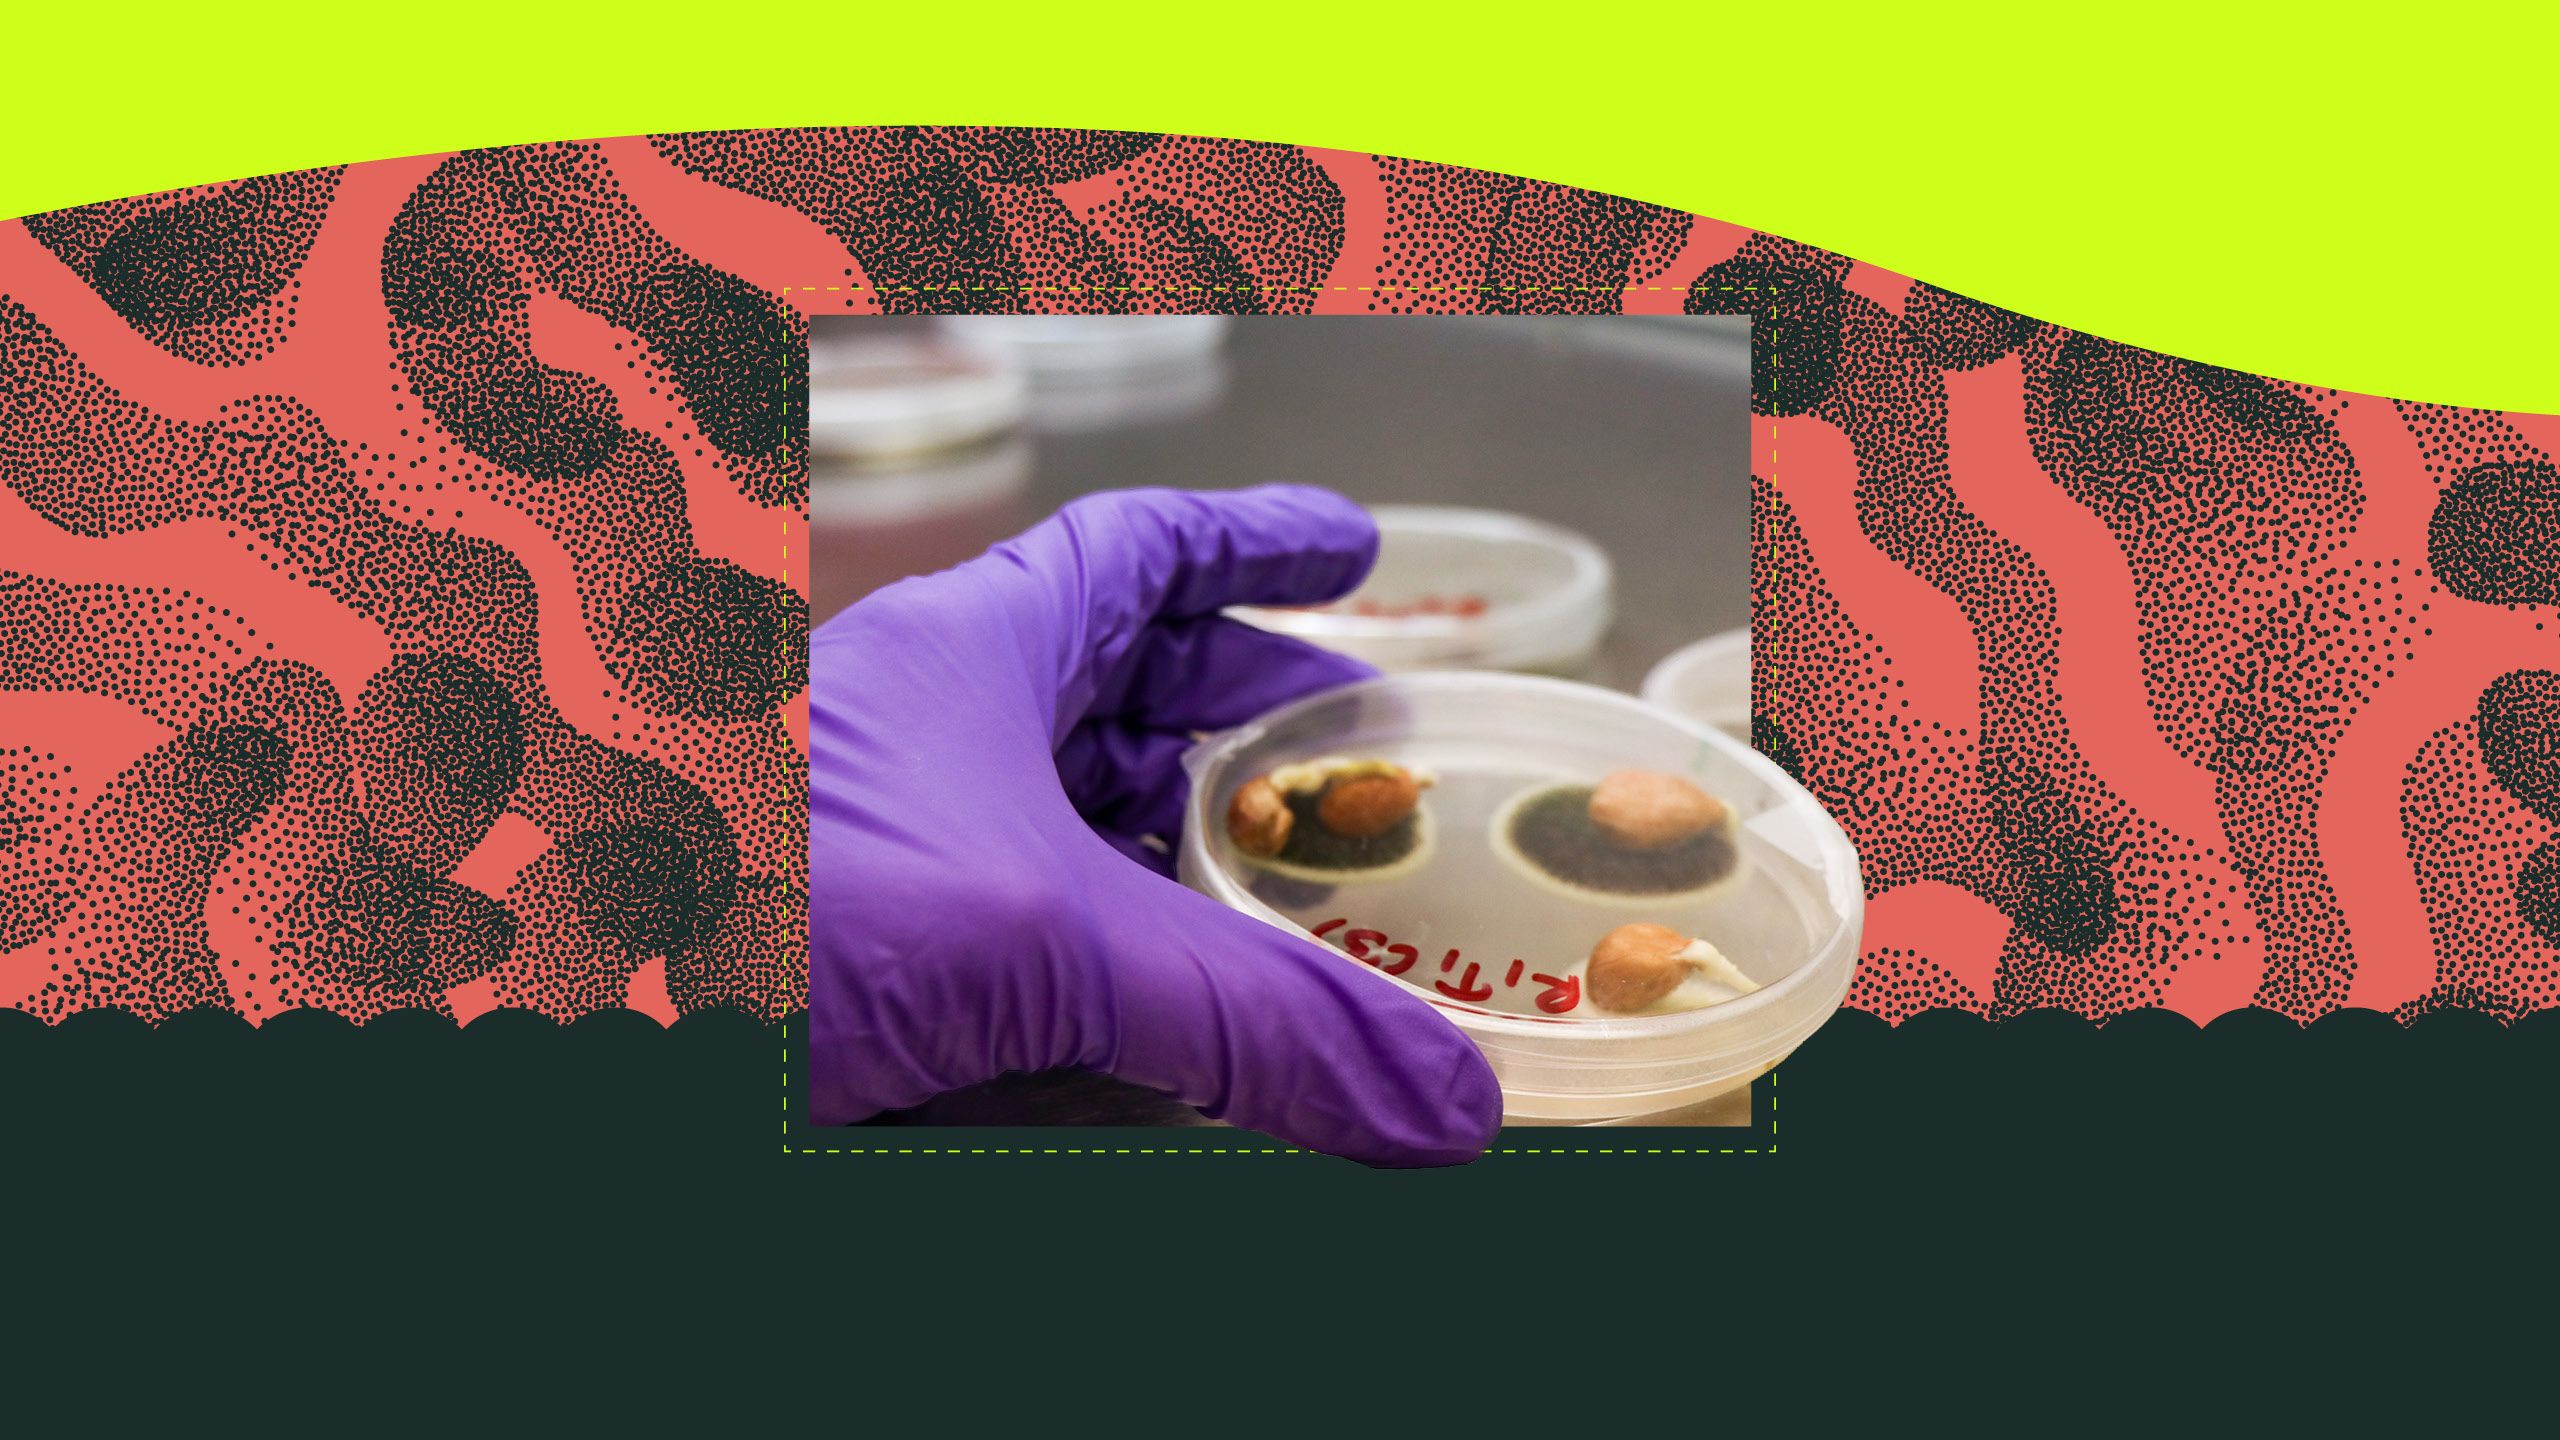
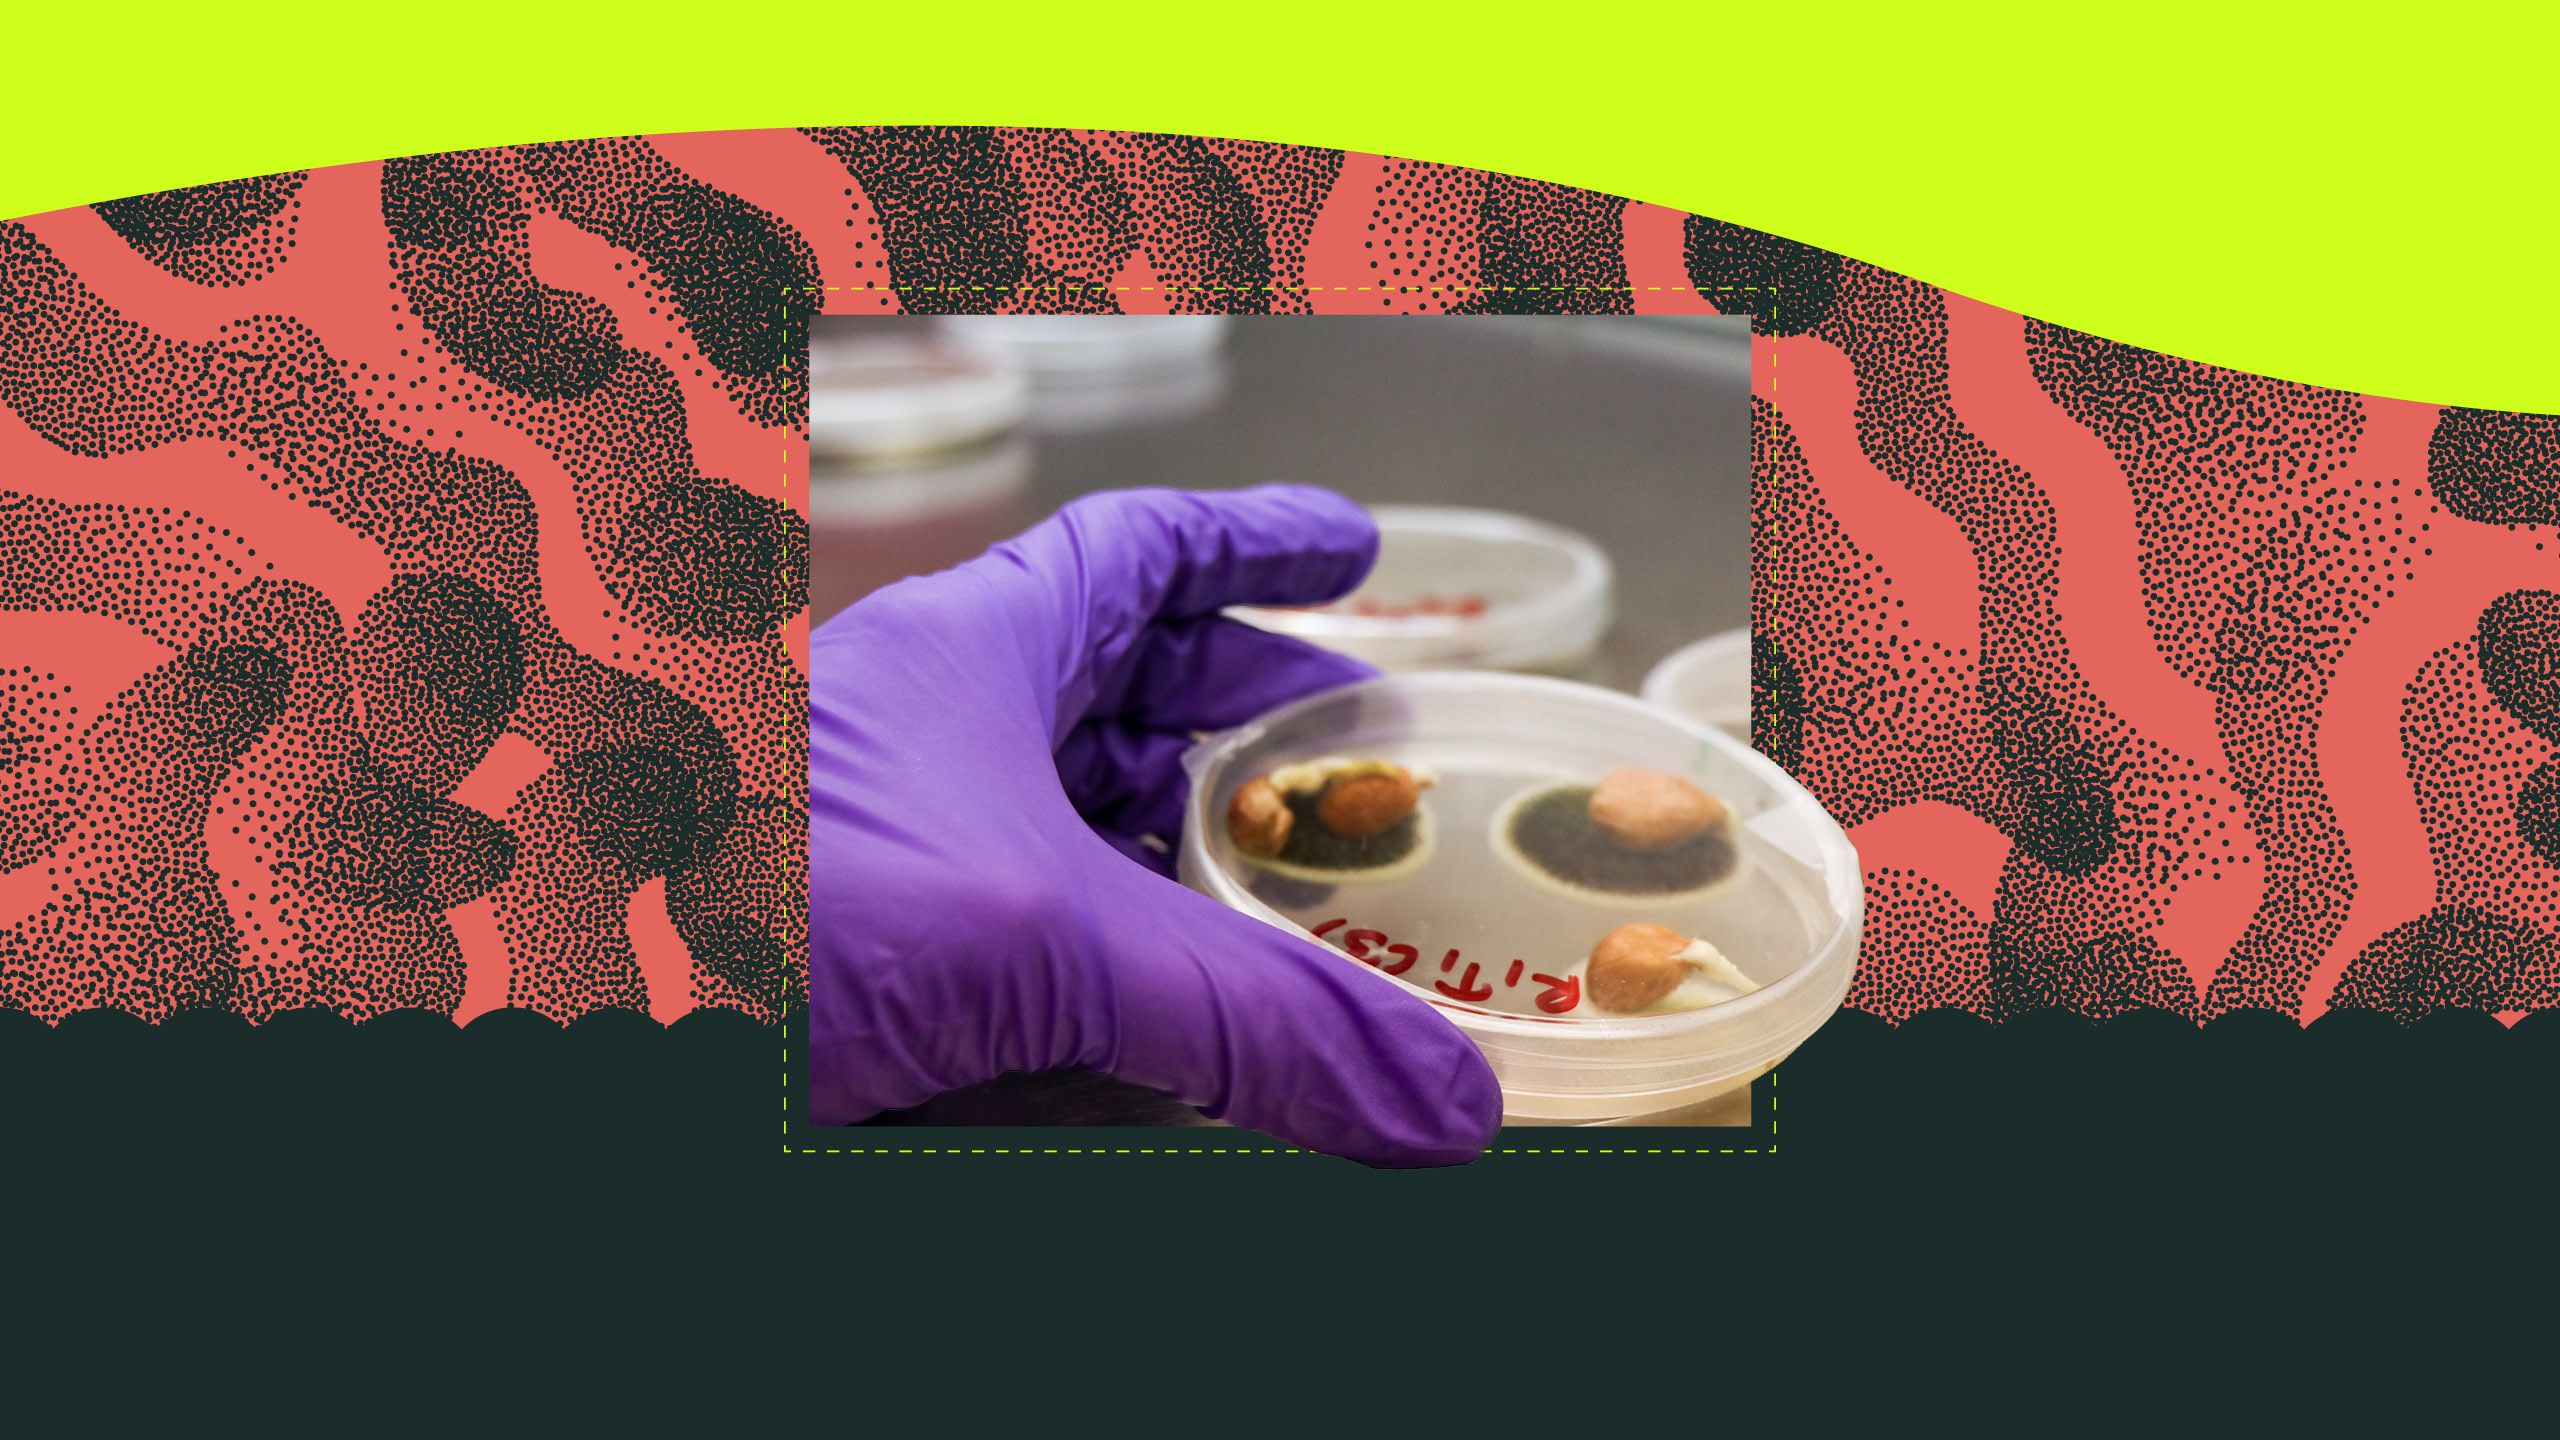

UGA DEPARTMENT OF PLANT PATHOLOGY
UGA forges path to understanding
plant disease

For more than a century, generations of researchers in the University of Georgia's Department of Plant Pathology have been at the leading edge of knowledge and innovation. As these researchers pass down their knowledge, their foundational scientific exploration helps safeguard crops, advance agricultural practices and ensure food security, not only in Georgia but far beyond its borders. The long-standing impact of their scholarship on the agricultural industry is a testament to the working legacy of plant pathology research programs.
The richly detailed, collaborative work stitches a quilt of intersecting research in quest of solutions to improve agriculture and solve known and emerging challenges. While it is impossible to elucidate the entirety of the department’s impact, we’ve highlighted a few of the most successful research legacies that have enhanced the agriculture industry over time.
Jump to each story using the navigation below.
Finding the Root
Plant-parasitic nematodes use spit to wreak havoc on crops.
Inset: Plant-parasitic cyst nematodes, stained red for visibility, infecting a root. (Photo by the Mitchum Lab)
Collaboration is Key
Georgia's peach industry was saved from an aggressive fungal disease through good chemistry.
Inset: If not managed, brown rot (Monilinia fructicola) can cause 100% crop loss in peaches. (Photo by Rebecca A. Melanson, Mississippi State University Extension, Bugwood.org)
Genetic sleuthing helps identify and combat novel plant pathogens.
Inset: Samples grow in a humidifier in the Brewer Lab. (Photo by Katie Walker)
Empowering Growers
A simple but powerful research-based tool helps peanut producers assess the risk of disease in their fields.
Inset: Georgia peanuts nestled in a petri dish.
Light micrograph of a second-stage juvenile root-knot nematode, Meloidogyne incognita. The spit secreted through the nematode’s hollow mouth stylet is stained blue.
Light micrograph of a second-stage juvenile root-knot nematode, Meloidogyne incognita. The spit secreted through the nematode’s hollow mouth stylet is stained blue.
Melissa Mitchum examines a soybean plant infected with soybean cyst nematode at her Tode Farm. (Photo by SCN Coalition)
Melissa Mitchum examines a soybean plant infected with soybean cyst nematode at her Tode Farm. (Photo by SCN Coalition)
Finding the Root
Deciphering how plant-parasitic nematodes use spit to wreak havoc
Nematodes are ubiquitous globally, and while most are considered to be beneficial soil organisms and pose no threat to plants, plant-parasitic nematodes are a grave threat to all economically important crops worldwide.
These microscopic roundworms produce secretions – or spit – through a protractible, hollow mouth stylet as a vehicle to parasitize a plant, feeding on living plant roots and causing substantial damage that weakens the plant's ability to absorb water and nutrients.
The female cyst nematodes feed and reproduce on plant roots. The adult female nematodes are visible on the root surface, as shown in the close-up image. (Photos by the Mitchum Lab)
The female cyst nematodes feed and reproduce on plant roots. The adult female nematodes are visible on the root surface, as shown in the close-up image. (Photos by the Mitchum Lab)
The results are stunted growth, reduced crop yields and even plant death. Each of the many species of plant-parasitic nematodes has its own host preference and mode of attack. This diversity of hosts and feeding lifestyles complicates production management strategies, requiring an integrated approach.
“Nematodes must be managed or their populations will continue to increase throughout the growing season and each year,” said Melissa Mitchum, a nematologist and professor of plant pathology in the College of Agricultural and Environmental Sciences.
Mitchum’s research builds on the groundbreaking work of Richard Hussey, emeritus distinguished research professor of nematology and her predecessor in the department. Beginning in the late 1980s, Hussey’s research focused on the significance of root-knot and cyst nematode spit in plant parasitism.
Richard Hussey (left) and then-assistant research scientist Guozhong Huang work in the lab circa 2006.
Richard Hussey (left) and then-assistant research scientist Guozhong Huang work in the lab circa 2006.
“Nematode secretions have the ability to circumvent the host plants’ defensive strategies and modify root tissues for feeding. Our research through the years has identified dozens of proteins in nematode spit that are critical for parasitic success, opening the door to potentially new strategies for nematode management,” said Hussey.
Building on Hussey’s findings of how nematodes use their spit to modify plant cells, Mitchum’s collaborative work in the Institute of Plant Breeding, Genetics and Genomics (IPBGG) focuses on engineering transgenic plants with resistance to plant-parasitic nematode spit.
That effort spills over into collaborations with UGA plant breeders to get more tools out to growers by developing high-yielding, nematode-resistant crop varieties.
“Honestly, it’s a really exciting time,” said Mitchum. “All of the targets we’ve identified through Hussey’s research and my own in understanding nematode secretions and plant defenses have brought us to a place in the research where we can finally employ modern plant genomic technology precisely.” She hopes these advancements will provide growers with a host of integrated management strategies to manage plant-parasitic nematodes more holistically.
The female root-knot nematodes feed and reproduce on plant roots, causing galls. The adult female nematodes, stained red in the close-up image, remain embedded in the gall. (Photos by the Mitchum Lab)
The female root-knot nematodes feed and reproduce on plant roots, causing galls. The adult female nematodes, stained red in the close-up image, remain embedded in the gall. (Photos by the Mitchum Lab)

The case of the exploding watermelons
Some questions cannot be answered overnight. A great many problems require decades of dedicated focus to fully unpack.
Now retired, UGA pathologist Ron Gitaitis began his research in 1991 looking for answers to how a disease called bacterial fruit blotch infects cucurbits. At the time, not much was known about the disease, only that it was found within the seeds of healthy fruit, primarily watermelon.
Bacterial fruit blotch had become a serious problem for growers in terms of crop loss, causing the rind of the fruit to burst and subsequently rot in the field, often described as “exploding.” A seed-borne disease, growers began suing seed companies for selling contaminated seeds. In turn, seed companies began suing the distributors, believing the disease had to have been picked up in transport, as they had seen no evidence of disease when growing the plants in their greenhouses. Gitaitis sought to resolve the litigious and scientific conundrum.
Ron Gitaitis, UGA professor emeritus
Ron Gitaitis, UGA professor emeritus
He had the idea that watermelon blossoms could be the pathway by which the pathogen entered the developing seeds within healthy fruit, but the burden of proving his theory required technology that was not yet advanced enough.
In 1995, he invited Ron Walcott to UGA to pursue his doctorate in search of that definitive proof. Walcott, now UGA’s vice provost for graduate education and dean of the UGA Graduate School, spent his first several years as a doctoral student performing field and lab work with Gitaitis. Eventually, they developed a new test to detect the bacterial pathogen in both the seeds and fruits of diseased plants.
“The really shocking discovery was that the bacteria can get into the female watermelon flower and infect the seeds without causing any bacterial fruit blotch symptoms on the fruit,” said Walcott. “Growers wouldn’t even know they had infected seeds. The pathogen could survive within the seeds of completely healthy-looking fruit, and be passed to the next grower, who would then see the evidence of bacterial fruit blotch on seedlings during the next growing season.”
The detection assay they developed helped the vegetable seed industry test their seeds before selling them to growers, the first step in the process of effectively managing the disease.
Walcott then explored how much bacteria moved from the flower to the seed, and how many bacteria were required on each seed to result in infected seedlings. His work on detection and transmission thresholds of the pathogen was critical for seed companies to produce clean seeds. Come time for seed harvest, the companies used the threshold data to minimize the risk of selling contaminated seeds to growers.
In turn, Walcott recruited Bhabesh Dutta as a doctoral student in 2007 to further investigate disease transmission and detection threshold as bacterial fruit blotch outbreaks were still occurring in growers’ fields despite the disease management efforts of the major seed companies. Their work helped justify recommendations for a much larger sample size for commercial seed health testing.
Dutta, now a professor of plant pathology at UGA, went on to continue the line of inquiry and found that the level of bacteria within the seeds was related to whether plants would develop symptoms in the field. Dutta explained that while the level of bacteria in some seeds may fall below the transmission threshold, plants will still develop disease symptoms under favorable environmental conditions.
Perhaps one of the most groundbreaking discoveries along the journey was finding where the pathogen survives in the seed.
“When the pathogen is introduced through the flower, it travels down the flower style with the pollen tube and gets embedded deep within the developing seed,” said Dutta. “When deeply embedded, it can survive seed treatments and is difficult to eradicate.”
Conversely, Dutta also found that the pathogen can be superficially located on watermelon seeds that are harvested from rotten fruits, where seed treatment is much more effective.
“If you produce seeds commercially, this is incredibly relevant, because even if you picked only healthy fruits, there is still a likelihood the seeds inside could be contaminated with this very devastating bacterium,” Walcott explained. “As you package, sanitize and send them around the world, you’re actually sending the pathogen around the world with them. So, the consequences are quite significant.”
These discoveries have changed how seed producers sample and sanitize seeds before they are sold based on whether the bacteria reside within or on the surface of infected seeds.
Dutta continues expounding on the research today, with graduate students and multidisciplinary partnerships throughout the Southeast working on a collective effort to improve watermelon production.
A cross section of a mature watermelon shows damage from bacterial fruit blotch (Acidovorax citrulli). (Photo by Gerald Holmes, Strawberry Center, Cal Poly San Luis Obispo, Bugwood.org)
A cross section of a mature watermelon shows damage from bacterial fruit blotch (Acidovorax citrulli). (Photo by Gerald Holmes, Strawberry Center, Cal Poly San Luis Obispo, Bugwood.org)
Plant pathologist Ron Walcott, now UGA's vice provost for graduate education and dean of the graduate school, poses for a photo at the Miller Learning Center in 2020. (Photo by Nancy Evelyn)
Plant pathologist Ron Walcott, now UGA's vice provost for graduate education and dean of the graduate school, poses for a photo at the Miller Learning Center in 2020. (Photo by Nancy Evelyn)
Bhabesh Dutta, UGA professor of plant pathology, found that the level of bacteria in watermelon seeds was related to whether the plant would later develop disease.
Bhabesh Dutta, UGA professor of plant pathology, found that the level of bacteria in watermelon seeds was related to whether the plant would later develop disease.
Collaboration is key to identifying and combatting plant disease.

From left, Harald Scherm, Dan Horton and Phillip Brannen examine crops in a peach orchard in Watkinsville, Georgia, at the UGA Horticulture Farm.
From left, Harald Scherm, Dan Horton and Phillip Brannen examine crops in a peach orchard in Watkinsville, Georgia, at the UGA Horticulture Farm.
Georgia's peach industry was saved by collaborative research to combat brown rot
“By chance, over the course of my tenure, I’ve worked with most fruit commodities currently grown in the state, so I’ve had the privilege of being part of several great success stories,” said Phillip Brannen, fruit pathologist for UGA Cooperative Extension.
When Brannen joined UGA as an assistant professor in plant pathology in 2000, the peach industry was being pummeled by a disease called brown rot. Through collaboration with Clemson University, Brannen identified that the problematic disease stemmed from resistance to the primary class of chemicals used to manage several other fungal pathogens in peaches.
Because brown rot can cause 100% crop loss if not controlled with fungicides, it was critical to quickly find new, effective chemical control options for growers. Through that collaborative work, the researchers developed new chemistries for peach growers to reduce resistance issues while effectively controlling brown rot. According to Brannen, the discovery effectively saved the peach industry.
After years of work addressing peach diseases, Brannen switched commodities as he began getting calls from growers about a type of leaf spot never encountered before in blueberries. When blueberry bushes develop these leaf spots early in the season, the fruit fails to fully develop, costing growers millions of dollars in losses.
“When you’re in the midst of the growing season and something new arrives, it can be absolutely devastating,” Brannen said. “Several people in our department worked with emerging plant diseases, and I began collaborating with a new mycologist in the department, Marin Brewer, to figure out what this novel pathogen was. It turns out that it had indeed never been identified. We had a lot of work to do to figure out what we were dealing with and how to manage it to save the blueberry industry.”
Following the discovery, Brannen, Brewer and a team of specialists were able to quickly find a control method for growers to employ early in the season before the fungal disease infects plants.
Brannen credits the success entirely to the collaboration across disciplines. “That’s how we get things done to support our agricultural producers — the multidisciplinary approach cannot be underestimated,” he said.
"I feel called to this career. Not everyone can say that," explained Brannen. (Photo by Emily Haney)
"I feel called to this career. Not everyone can say that," explained Brannen. (Photo by Emily Haney)


Undergraduate students Christian Ona (left) and Natalie Miller (right) examine spores with a microscope as Brewer looks on. (Photo by Katie Walker)
Undergraduate students Christian Ona (left) and Natalie Miller (right) examine spores with a microscope as Brewer looks on. (Photo by Katie Walker)
Exobasidium leaf spot symptoms on the lower canopy of ‘Premier’ rabbiteye blueberry in Alma, Georgia.
Exobasidium leaf spot symptoms on the lower canopy of ‘Premier’ rabbiteye blueberry in Alma, Georgia.
Master's student Laxmi Pandey examines growth of seed-borne peanut pathogens, including some Aspergillus species, in Brewer’s mycology lab. (Photo by Katie Walker)
Master's student Laxmi Pandey examines growth of seed-borne peanut pathogens, including some Aspergillus species, in Brewer’s mycology lab. (Photo by Katie Walker)
Shedding light on fungal disease
Tracing the lineage of UGA mycologists back to the 1950s, the microscopic yet mighty work of identifying, naming and characterizing fungal pathogens helps farmers understand diseases in the field.
One such clade of fungi is the ascomycetes. The largest group of fungi present throughout the world, ascomycetes impact a variety of important agronomic and ornamental crops, causing disease and costing billions of dollars in crop loss and management efforts each year.
When those in the field think they have encountered a fungal disease caused by a new species, UGA mycologist Brewer does the taxonomical and genetic work to help identify whether it’s a new pathogen.
“I’m more interested in knowing how a new disease comes to be,” said Brewer, William Terrell Distinguished Professor in plant pathology. “I want to know if it was introduced from somewhere else, or if it evolved resistance to fungicide over time, or if it is in fact a new species that’s never been discovered or described before.”
Posing those questions helps researchers understand where a pathogen came from, learn how to minimize its introduction, and improve management practices once the disease is established.
An example of such work, described earlier by Brannen, was the novel fungal pathogen that plagued the blueberry industry in 2006. Brewer worked with colleagues to fully characterize the new fungus, and in 2014 officially named it Exobasidium maculosum — commonly referred to as Exobasidium leaf and fruit spot.
Brewer has received funding to fully determine how another fungal pathogen, Aspergillus fumigatus, develops resistance to a common chemical fungicide used in agriculture. When inhaled, spores from the pathogen, found on decaying plant matter, can be life-threatening for immunocompromised individuals because it has become resistant to currently available antifungal medications.
“This is a bit outside of the realm of agriculture, but the link between how growers manage disease in the field to how medical practitioners treat disease in humans is quite fascinating and presents us with a grand challenge,” said Brewer. “That work is continuing to unfold, and we’ve got a great, multidisciplinary team looking to find the best, most balanced response so our growers don’t lose their crops and people don’t lose lives.”

Science is a powerful tool in the hands of growers.
Bob Kemerait gives a seminar at the 2022 Georgia Peanut Tour. (Photo courtesy of the Georgia Peanut Commission)
Bob Kemerait gives a seminar at the 2022 Georgia Peanut Tour. (Photo courtesy of the Georgia Peanut Commission)
Tomato spotted wilt virus stunts the growth of peanut plants, resulting in small, darkened pods. (Photo by Steve L. Brown, University of Georgia, Bugwood.org)
Tomato spotted wilt virus stunts the growth of peanut plants, resulting in small, darkened pods. (Photo by Steve L. Brown, University of Georgia, Bugwood.org)
A practical program for peanut growers
For Bob Kemerait, the measure of merit in his field is seeing the growers he serves succeed year after year.
A professor and Extension row crop disease specialist, Kemerait is the program coordinator of a tool called the Peanut Disease Risk Index — commonly referred to as Peanut Rx.
The genesis of the tool, he said, was born out of decades of multidisciplinary work examining the most important factors for successfully growing peanuts.
In 1997, a disease called tomato spotted wilt virus threatened the peanut industry, with record-breaking losses being incurred throughout the southeast. A diverse team of faculty from UGA, University of Florida and Auburn University came up with the idea that in place of a single solution from any one field of practice, they would create a resource to combine all the various risk factors and recommendations to be considered as a whole. The tool was then expanded to assess the risk for leaf spot and white mold diseases.
Farmers examine a peanut field infected with tomato spotted wilt virus in 2008. (Photo by Steve L. Brown, University of Georgia, Bugwood.org)
Farmers examine a peanut field infected with tomato spotted wilt virus in 2008. (Photo by Steve L. Brown, University of Georgia, Bugwood.org)
The index, which contains 37 metrics deemed most critical for peanut production, allows growers to rate themselves from low to high risk based on how environmental and field conditions, coupled with their specific production practices will decrease or increase their chance of disease development. Along with the tool, faculty produce annual publications and provide regular training sessions to educate peanut growers on current best practices for minimizing diseases — which ultimately improves yields and profits.
“If you were to ask any grower in Georgia which peanut variety, insecticide, tillage practice or planting date is best to reduce risk to tomato spotted wilt, they will know the answers to all of those questions,” said Kemerait. “To me, that is the epitome of success. That tells me we are doing our jobs and empowering people by providing the best information possible for the best outcome possible, year after year.”
“It’s a win-win situation,” said Kemerait. “By helping producers achieve and maintain a lower risk for diseases, using the tool also helps minimize the amount of inputs needed.”
Across the board, the agricultural chemical industry supported the use of the tool, even if it meant that growers may not need to rely as heavily on chemical inputs.
“Ultimately, the companies believed what is best for growers is best for them as well,” he added. “They believe in the research and with their buy-in, the Peanut Rx logo now accompanies much of the material peanut growers receive from them. It’s helped ingrain this tool as part and parcel to growing peanuts.”
For nearly 30 years, Peanut Rx remains a highly utilized, highly appreciated tool that has been used as a model throughout the country for other commodities looking to improve yields.
“The reason more commodities haven’t adopted this model is that it requires a lot of research and a lot of Extension activity,” said Kemerait. “For that, I couldn’t be more proud. We have a lot of unsung heroes in this success story, all working in tandem to help growers prosper.”

Plant pathologist Alfredo Martinez-Espinoza lectures during the 2018 Turfgrass Research Field Day at UGA's Griffin campus.
Plant pathologist Alfredo Martinez-Espinoza lectures during the 2018 Turfgrass Research Field Day at UGA's Griffin campus.
Leading the way in turf
In 1999, Professor Alfredo Martinez-Espinoza started his tenure at UGA as a research scientist in fungal genetics, studying the development and transfer of information and management of disease in turfgrass, grass forages and small grains. His primary research focus over the years has narrowed in on turfgrass.
“The interesting thing,” said Martinez-Espinoza, “is turfgrass is completely different from other areas under the umbrella of agriculture. It’s all about engaging emotions, improving aesthetics, enhancing playability and increasing quality.”
In 2008, in the footsteps of retired turfgrass pathologists Lee Burpee and Ed Brown, he began documenting fungicide resistance in turfgrass pathogens. Decades later, that line of research continues to be one of the main concerns for the industry.
“There are always going to be new pathogens that emerge, or pathogens that already exist but are re-emerging, or they occur in other systems and are now present in turfgrass,” he said. “That’s part of the reason we see so many issues with fungicide resistance because it’s nearly impossible not to use chemical inputs to manage disease, especially in the Southeast.”
Turfgrass grows in a greenhouse at UGA-Griffin.
Turfgrass grows in a greenhouse at UGA-Griffin.
Fortunately, as the body of plant disease research grows, disease models are used to inform researchers and specialists of existing findings to more quickly respond to breakouts of disease and prevent the spread, Martinez-Espinoza said.
“There are several stories of innovative turfgrass pathology research and extension at UGA, but one of my favorite successes has been to be part of the development of a turfgrass app, called Turfgrass Management, said Martinez-Espinoza.
He said the UGA turf program was the first in the country to develop an app-based model for disseminating peer-reviewed management information.
“While it isn’t part of a research program, this was the very first, peer-reviewed app available, so we had essentially repackaged our research-based information in a unique way, and it was developed completely in-house by the team,” he added.
Supporting Martinez-Espinoza’s assertion that research-based information should be available to everyone, he is active in international outreach and has recently joined the newly established Spanish Professional Extension Committee to help translate publications and other materials and training events to reach Spanish speakers throughout the state.
For more information about plant pathology at UGA, visit plantpath.caes.uga.edu.